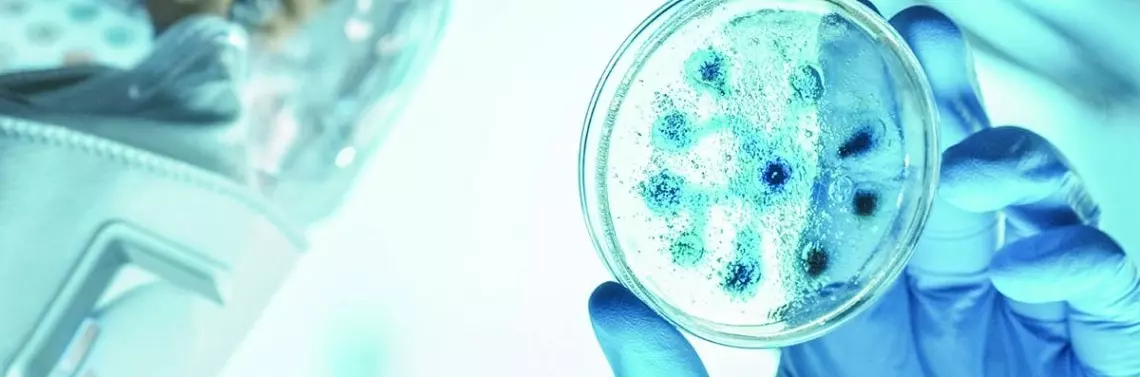

O powszechności występowania tych cząstek zakaźnych może świadczyć fakt, że materiał genetyczny człowieka zawiera około 100 tysięcy fragmentów pochodzenia wirusowego, co stanowi 8% ludzkiego genomu. Wiele z wirusowych elementów zostało wprowadzonych do materiału genetycznego naszych przodków już miliony lat temu i od tamtej pory są one dziedziczone przez kolejne pokolenia. Najpowszechniej identyfikowane sekwencje wirusowe w genomie ludzkim pochodzą od endogennych retrowirusów (HERV). Postuluje się, że mogą stanowić źródło fizjologicznych różnic między ludźmi, które przyczyniają się do podatności na określone choroby, ponieważ fragmenty kodowane przez HERV wykazują wyższą ekspresję u pacjentów dotkniętych stwardnieniem zanikowym bocznym (ALS lub choroba Lou Gehriga), stwardnieniem rozsianym i kilkoma typami nowotworów, a produkty ich genów mają wpływ na etiologię lub progresję tych chorób. Wykazano także, że niektóre HERV-y są kluczowe dla prawidłowej regulacji ludzkiej odpowiedzi immunologicznej.
Wirusy odkryto po raz pierwszy po opracowaniu porcelanowego filtra zwanego filtrem Chamberland-Pasteur, który mógł usunąć wszystkie bakterie widoczne w mikroskopie w dowolnej próbce cieczy. W 1886 r. Adolph Meyer badał sposób przenoszenia choroby tytoniu i wykazał, że choroba mozaiki tytoniu może być przenoszona z chorej rośliny na zdrową za pośrednictwem płynnych ekstraktów roślinnych. Okazało się, że ekstrakty nie utraciły swojej chorobotwórczości nawet po odfiltrowaniu wszystkich bakterii (eksperyment przeprowadzony w 1892 r. przez Dmitria Ivanowskiego). Jednak minęło wiele lat, zanim udowodniono, że te filtrowalne czynniki zakaźne nie były po prostu bardzo małymi bakteriami, ale nowym typem maleńkich wywołujących choroby cząsteczek zwanych później wirusami.
Chociaż biolodzy zgromadzili znaczną ilość wiedzy na temat ewolucji współczesnych wirusów, niewiele wiadomo na temat pochodzenia tych cząstek, ponieważ brak jest w tym przypadku materiałów kopalnych i historycznych. Większość ustaleń mówi o tym, że wirusy nie mają jednego wspólnego przodka, jednak badacze nie znaleźli jeszcze jednej hipotezy dotyczącej pochodzenia wirusa, która byłaby w pełni akceptowana. Jedna z możliwych hipotez, zwana dewolucją lub hipotezą regresywną, proponuje, że wirusy wyewoluowały z wolno żyjących komórek. Jednak nie jest jasne, jak dokładnie mógł się ten proces odbywać. Druga hipoteza (zwana hipotezą eskapistyczną lub progresywną) sugeruje, że wirusy pochodzą z cząsteczek RNA i DNA, które „uciekły” z komórki gospodarza. Natomiast trzecia hipoteza zakłada, że wirusy ewoluowały wraz z komórkami gospodarzy. Badania niektórych patogenów roślinnych potwierdzają tę hipotezę.
Zatem wirusy towarzyszą nam od początku istnienia, wpływając na nas samych i otaczające nas organizmy.
W głównej mierze wirusy składają się z materiału genetycznego – DNA lub RNA (dwu lub jednoniciowego) chronionego przez kapsyd – otoczkę białkową. W zależności od rodzaju wirusa na powierzchni cząstki mogą znajdować się także lipidy lub glikoproteiny. Budowa cząstek wirusowych wykazuje dużą różnorodność, wyróżnia się formy helikalne, kubiczne czy złożone. Wirusy o budowie helikalnej mają kształt pałeczkowaty, wydłużony. Mogą być stosunkowo krótkie i bardzo sztywne albo wręcz długie i elastyczne, podczas gdy cząstki o symetrii kubicznej mają strukturę o dwudziestu trójkątnych ścianach i dwunastu wierzchołkach. Wszystkie zwierzęce wirusy zawierające DNA mają kapsydy o takim kształcie (poza pokswirusami). Choć większość wirusów można przypisać do jednej z dwóch powyższych kategorii, niektóre wirusy nie pasują ani do jednej, ani do drugiej. Określa się je wirusami o symetrii złożonej, do których należą m.in. pokswirusy. Klasyfikacja wirusów jest bardzo trudną kwestią i odbywa się na podstawie rodzaju kwasu nukleinowego, jego postaci, polarności genomu, symetrii budowy oraz występowania otoczki lipidowej.
Rozmiary wirusów mierzy się w nanometrach. Skalę, o której mowa najlepiej ilustruje fakt, że milion nanometrów składa się na jeden milimetr oraz porównując wielkość wirusów do rozmiarów, powszechnie występujących bakterii. I tak na przykład przy średnicy 220 nanometrów wirus odry jest około 8 razy mniejszy niż bakteria E. coli, a wirus zapalenia wątroby (45 nm średnicy) jest od niej mniejszy aż 40 razy. Nie dziwi zatem fakt, że jak wspomniano już wcześniej, wirusy są zdolne do infekowania wszystkich form życia.
Te cząsteczki, które infekują bakterie, noszą miano fagów lub bakteriofagów. Ich genom może być zbudowany zarówno z DNA lub RNA, ale członkowie tej grupy wykazują bardzo dużą różnorodność w budowie, często z dużymi zniekształceniami, zatem trudno jest wyróżnić w tej grupie cechy wspólne. W tym przypadku podczas infekcji mówimy o cyklu litycznym (kończącym się śmiercią zainfekowanej komórki) lub lizogenicznym, gdzie wirus wbudowuje swój materiał genetyczny do genomu gospodarza i pozostaje w formie uśpionej.
Infekcje wirusowe roślin są również bardzo powszechne i są powodem ich zwiększonej podatności na wszelkiego rodzaju stresy środowiskowe biotyczne i abiotyczne, takie jak susza, wysoka temperatura, mróz czy ataki patogenów lub szkodników, powodując tym samym obniżenie plonowania zbóż czy jakości warzyw i owoców. W dużej większości wirusy roślinne zawierają jednoniciowy RNA jako materiał genetyczny i zwykle pozbawione są otoczki lipidowej, a infekcja m...
Wirusy
Wirusy to groźne mikroskopijne cząsteczki zakaźne, które od milionów lat występują na całej planecie i mogą zakażać wszystkie formy życia (zwierzęta, rośliny, grzyby i bakterie). Co ciekawe, nie są uważane za organizmy ze względu na brak budowy organellowej i maszynerii molekularnej niezbędnej do replikacji i produkcji własnych białek. Przetrwanie zapewnia wirusom pasożytniczy tryb życia i wykorzystywanie molekularnych systemów w komórkach zainfekowanego gospodarza.
Jeśli posiadasz już konto, zaloguj się.